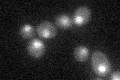
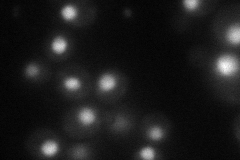

View description
Ty1 enhancer activator required for full levels of Ty enhancer-mediated transcription; C6 zinc cluster DNA-binding protein
Localization:
Intensity:
Fold change:
Significance:
-
C’ GFP library in SD
nucleus25.43 -
N' NOP1pr-GFP in SD
nucleus58.777 -
N' TEF2pr-mCherry in SD

nucleus49.2313 -
N' NATIVEpr-GFP in SD

nucleus26.8645 -
N' TEF2pr-VC and Cyto-VN in SD

nucleus41.203 -
C’ GFP library in SD+DTT

nucleusN/AN/ANo -
C’ GFP library in SD+H2O2

technical problem0N/ANo -
C’ GFP library in Starvation Media

nucleusN/AN/AYes -
C’ GFP library on the background of Pup2-DaMP

nucleus -
C’ GFP library on the background of CCT mutant

nucleusN/AN/ANo
